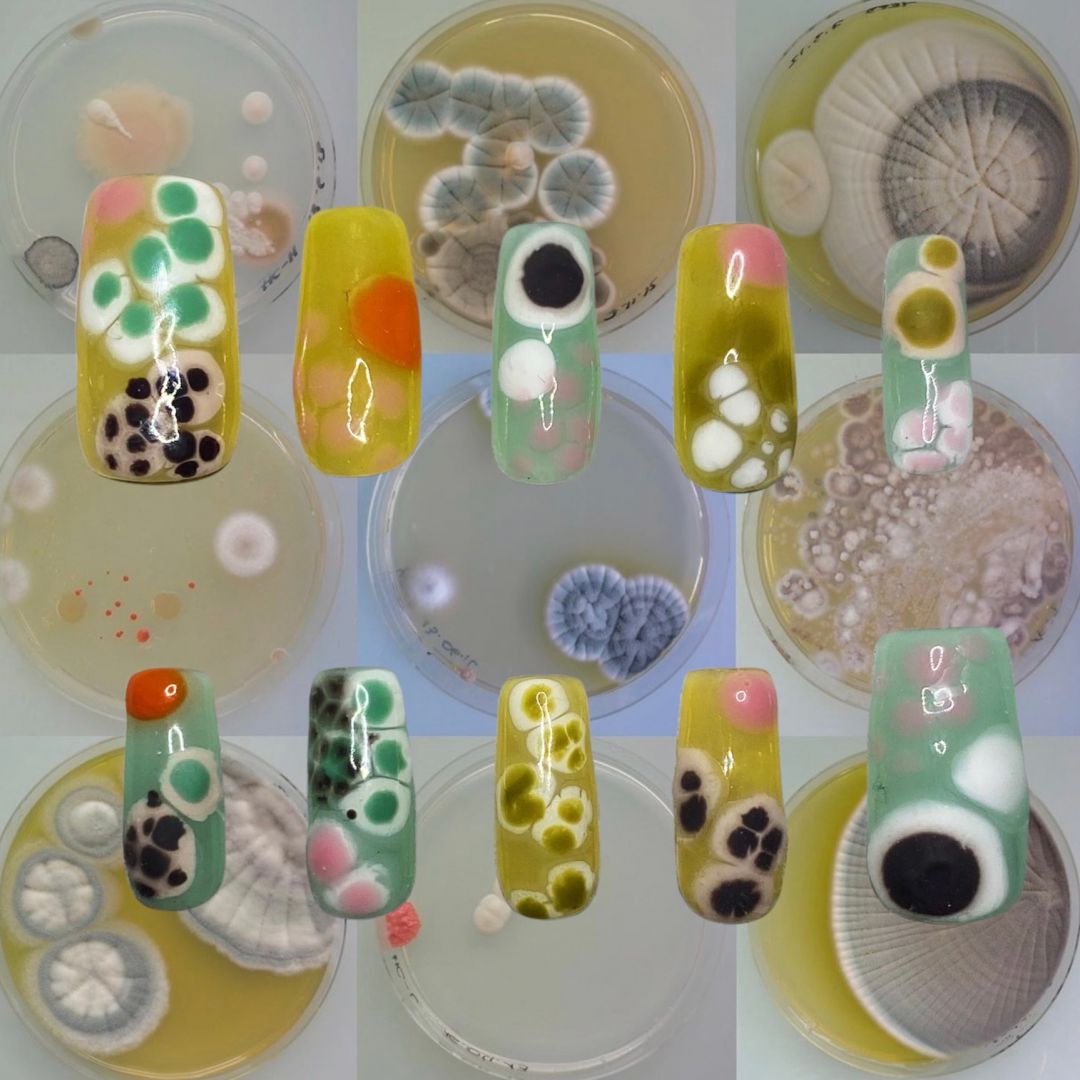

What is the Most Important Factor Behind Your Success?

We asked the community what factors they felt were responsible for their success and we’ve highlighted some of those responses below.

Growing up in the great northern city of St. Petersburg Russia, I was influenced by its melancholy beauty and architecture leading to my (near) obsession with fantasy art. My passion and effort to emulate fantastical worlds with unique characters has been key to my brand’s awareness. When I initially began KT Dolls (ktdolls.com) I focused exclusively on unique “one-of-a-kind” art dolls which primarily attracted the attention of galleries in Europe and the States. As I expanded my interests and portfolio, I’ve been fortunate that my art dolls, jewelry, and puppet work for animation have resonated with a broader audience leading to success beyond just galleries. Read more>>

Resilience, for sure. I’ve had a to rebuild and pivot so many times in my life. I originally thought I wanted to be an actor, which ultimately led to 10 year career in non-profit management and fundraising for major celebs. I did that while building a career as a writer, publishing four books and contributing to sites like POPSUGAR and Men’s Health. Then I ultimately landed myself in this current role of being a leading pop-culture podcaster. But it was all about that resilience to take every ‘no’ and continue to find new ways to break down barriers in whatever industry I found myself in. That tenacity is what got me everything I have today. Read more>>

I think the most important factor in the success of my brand has been to operate from a place of love. It’s important to do things for the overall well-being of the community. Being a genuine person and following that internal moral compass allows one to shine light onto others. When you project love you receive love, so many of the opportunities that we don’t have are really opportunities that we don’t get because we’re not allowing ourselves to unlock them. Love yourself care for yourself because it inspires you to level up to take the extra course to get the next degree. The right people will be drawn to you, people will want to be part of your world. Read more>>

I consider myself to be intuitive and believe that’s an essential element to my success as a brand leader. It’s as if I have an ear to the ground and I’m a conduit, using my personal experience to understand the needs of what the consumer wants and how to interpret that through product. Because the foundation of my fashion career began in sales, I also have the ability to analyze our sales performance, interpret what that potential means on a larger scale, Read more>>

One significant factor behind my success is not giving up. Being my own boss means I can schedule when I want to work and how long, which leads to how much money I can make. There are times when I have events that barely make my week or online sales are not coming in as expected. When this happens, the fear of not making enough to cover business expenses or not making enough for personal bills starts to creep, and suddenly, the idea of giving up on myself may come to mind. I’ve had this happen multiple times in my business, where I feel like quitting and going back to working a “regular” job. Read more>>

I hesitate to use the word success, but I can tell you what my process has been thus far – a few things – Firstly, for my solo music specifically (and/or my work under my own name and not pseudonyms), it’s been how easy it feels to create when you find the right people on your team. For my bands and/or solo work, I don’t love to work with people I couldn’t envision myself at least grabbing a cup of coffee with. When you are fans of each other, it shows. Of course there are cases where hard things come up and you just need to push through them, but if the cons end up outweighing the pros and when and it’s not fun anymore, sometimes, it’s just time to let something go, especially if there’s some sort of friendship as a base there. Read more>>

I believe finding your point of difference in a world full of choice is beneficial to success – Find what inspires you, what makes you weird, what makes you wonderful, what makes you want to draw and create, what makes you not want to put the paint brush down. Success came when I stopped painting what I thought people wanted to see, stopped focusing on what colours were classified as ‘on-trend’, stopped playing it safe and limiting what I wanted to paint versus what I thought would sell, stopped analysing every painting and wondering if it is as good as those I look up to… Success came when I stopped over-thinking. Read more>>

Community. Terasaki Budokan is located in Little Tokyo, DTLA. The residents, business owners, cultural institutions, etc. here in our community contribute to a lively and energetic ecosystem that we all thrive in and off of. But in addition to our physical community.. Read more>>

Inner belief. I have always “known” I was going to be an artist of some sort. I had this feeling from as early as I can remember. It’s hard to put into words, but there it always was. Charles Bukowski wrote a famous poem about a “little bluebird” inside of him that kept singing despite the alcohol and cigarettes he poured down on, and choked it, with. My feelings regarding my “art core” are similar. Looking back on the turns of fate and fortune in my life, every road led to my Rome; it was only a matter of seeing these events, both seemingly favorable, and not, as sign posts to my present. Read more>>

All of my businesses have been started around a deeply rooted WHY. When I was a part of the corporate world and just another name on payroll, I’d always hear business exec’s express how important it was to have a WHY behind what you were doing. I never applied it in that setting because it didn’t feel exciting to say “I’m here to pay my bills”, but as a small business owner the reason behind the scenes is my lifeline. I’ve always created business that have a reason, a story and a motivating factor for me and always created businesses that tie that into my community. My WHY for my most recent endeavor is to give back to mental health awareness organizations and shine a light on what’s good in our day to day life. It’s something that not only I relate to, but many others and allows me to meet people where they feel comfortable. Read more>>

The most important factor behind Proven LA’s (formerly MadeByMia) success is organization and planning. I always take the time to plan every aspect of every drop meticulously. I begin by choosing a release date for my new collection and work backwards from there in order to adequately plan photoshoots, photo editing days, marketing rollout, and actual production. I set dates for when I want designs to be done, models selected, and garments to be purchased. This planning ensures for a more efficient drop day – when that day arrives I can easily pack and prepare orders to be shipped out. Having a concrete plan also serves to motivate me and provides structure. Read more>>
Confidence and drive We’ll always be our own worst critics. We’re so used to our own work that we always underestimate how it appears to others. To run a brand, however, you need to have the confidence to find your footing in your industry and put out your work into the world. You need to be confident in your identity, your product, your marketing, your platform, your audience, and your ideas to be able to sell it to someone else. Once you have it the rest is drive. How badly do you want to see success? How will you consistently deliver quality? Are you willing to make changes by listening to your consumer base? Read more>>

My uncharted determination and positive outlook. I am faced with challenges, self-doubt, and people telling me “no” everyday, but I don’t let any of those things stop me. When a challenge arises, I look at it as an opportunity to learn something new so that next time, it isn’t a challenge. When I doubt myself (which happens A LOT), I break down my long term goals into smaller goals that are more manageable on the day to day. When I get rejected by brands or venues, I remember that it is their loss and that soon, I’ll hear a “yes.” My outlook allows me to stay disciplined and keep going even when it gets rough, and that is when it really matters most. Read more>>

The most important factor behind our success is that we adapt. When the pandemic hit we had to cancel all of our shows. We were stuck wondering what we could do. We decided that the best way to continue to reach an audience is by making videos. Danny got really into videography. He learned how to use Adobe Premiere and the two of us started making videos. Our biggest success was when we released a 360 music video of our song Silverspoon. It got half a million views in just a few months. Read more>>

Success is a nuanced topic for me. On one hand, success can be measured by income, wealth or financial standing. I certainly have specific markers that I look for to achieve success. However, I also have an understanding of success that exists without a focus on income or money at all. That understanding revolves my overall satisfaction with what I do and how I help others. Both aspects hold equal weight, but I must say that I have more joy and peace when I focus on the latter. Read more>>
